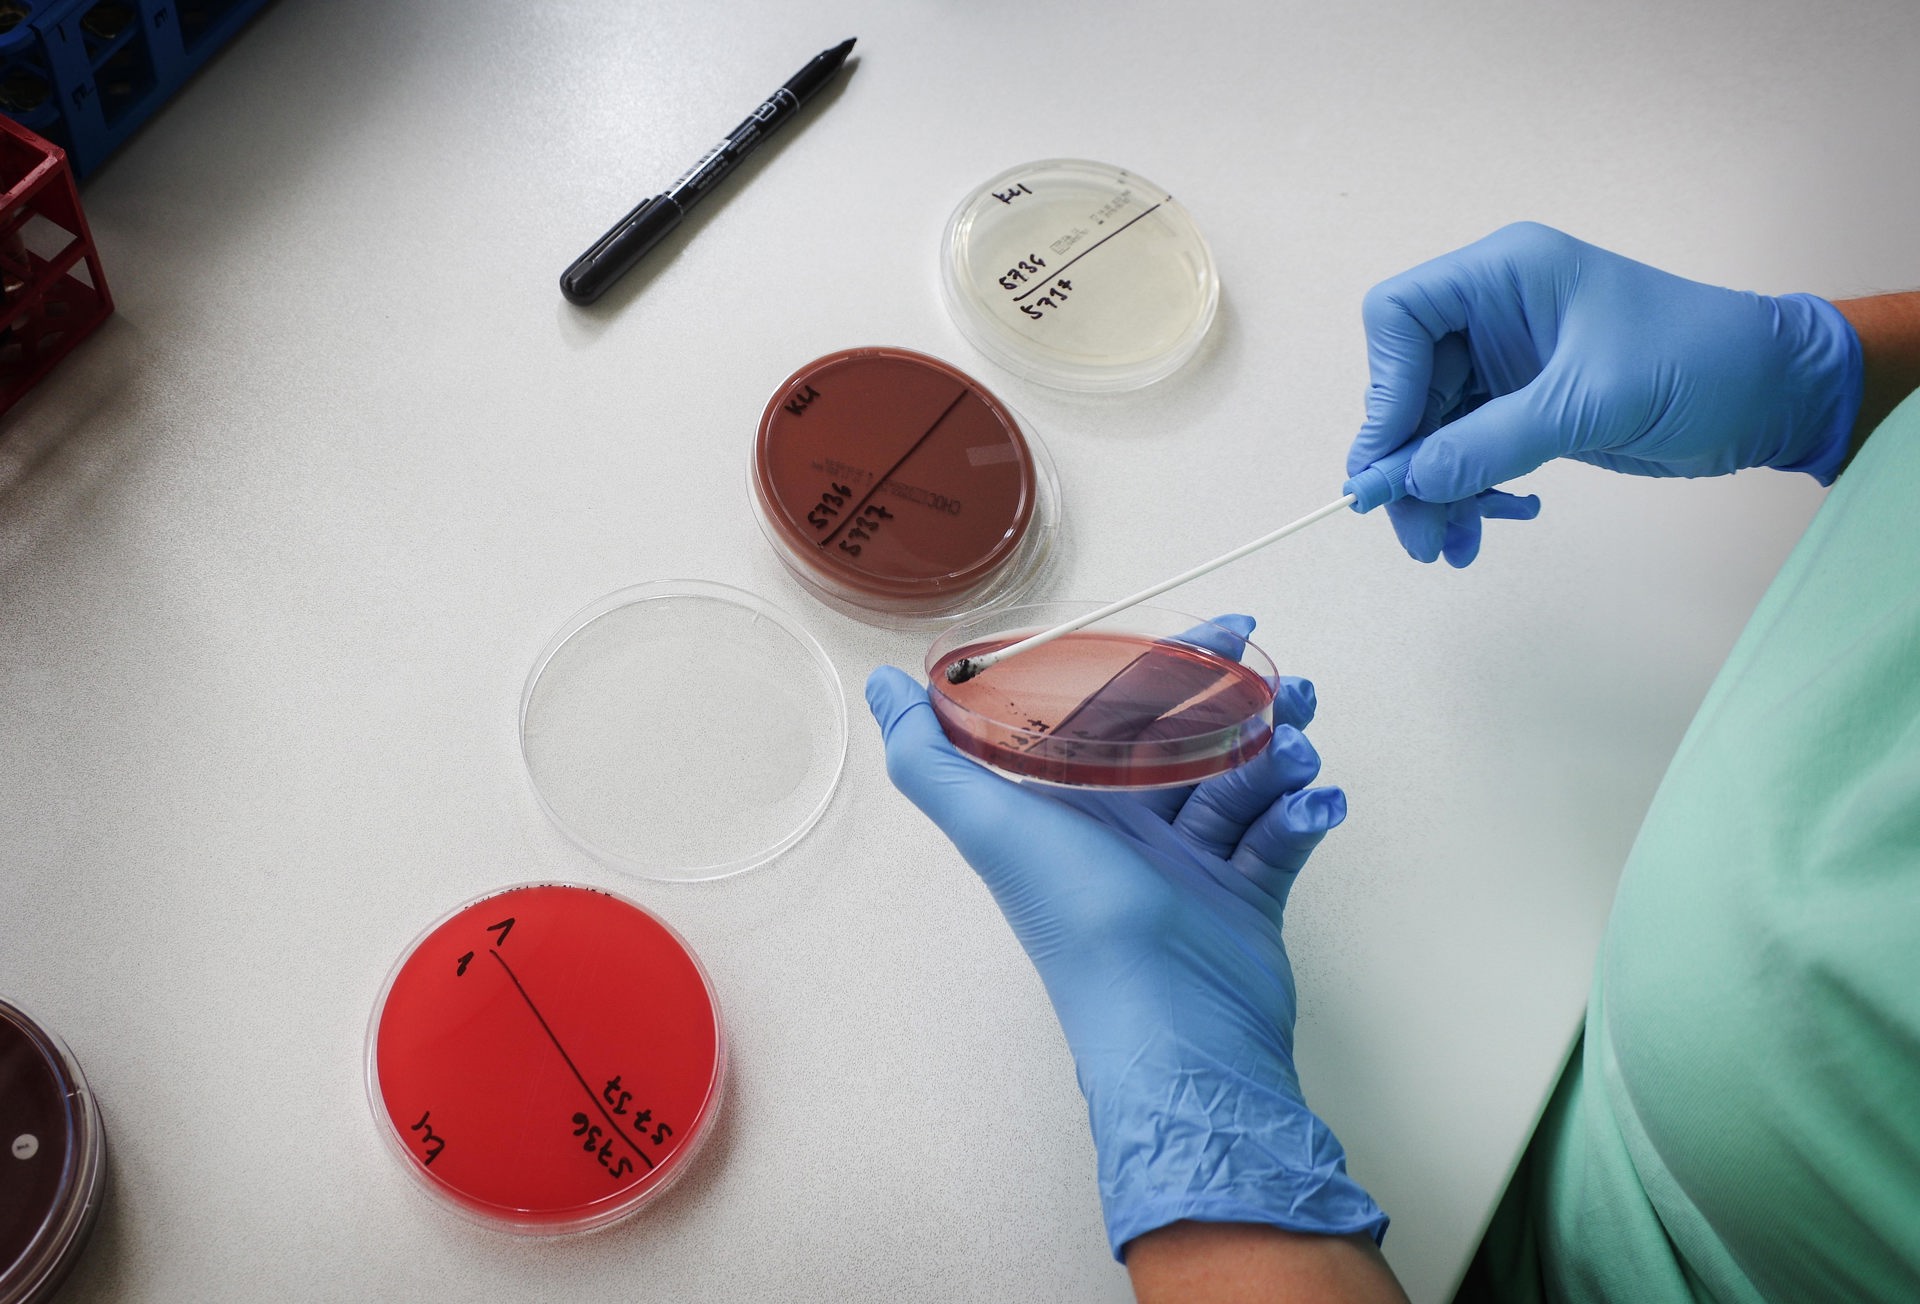
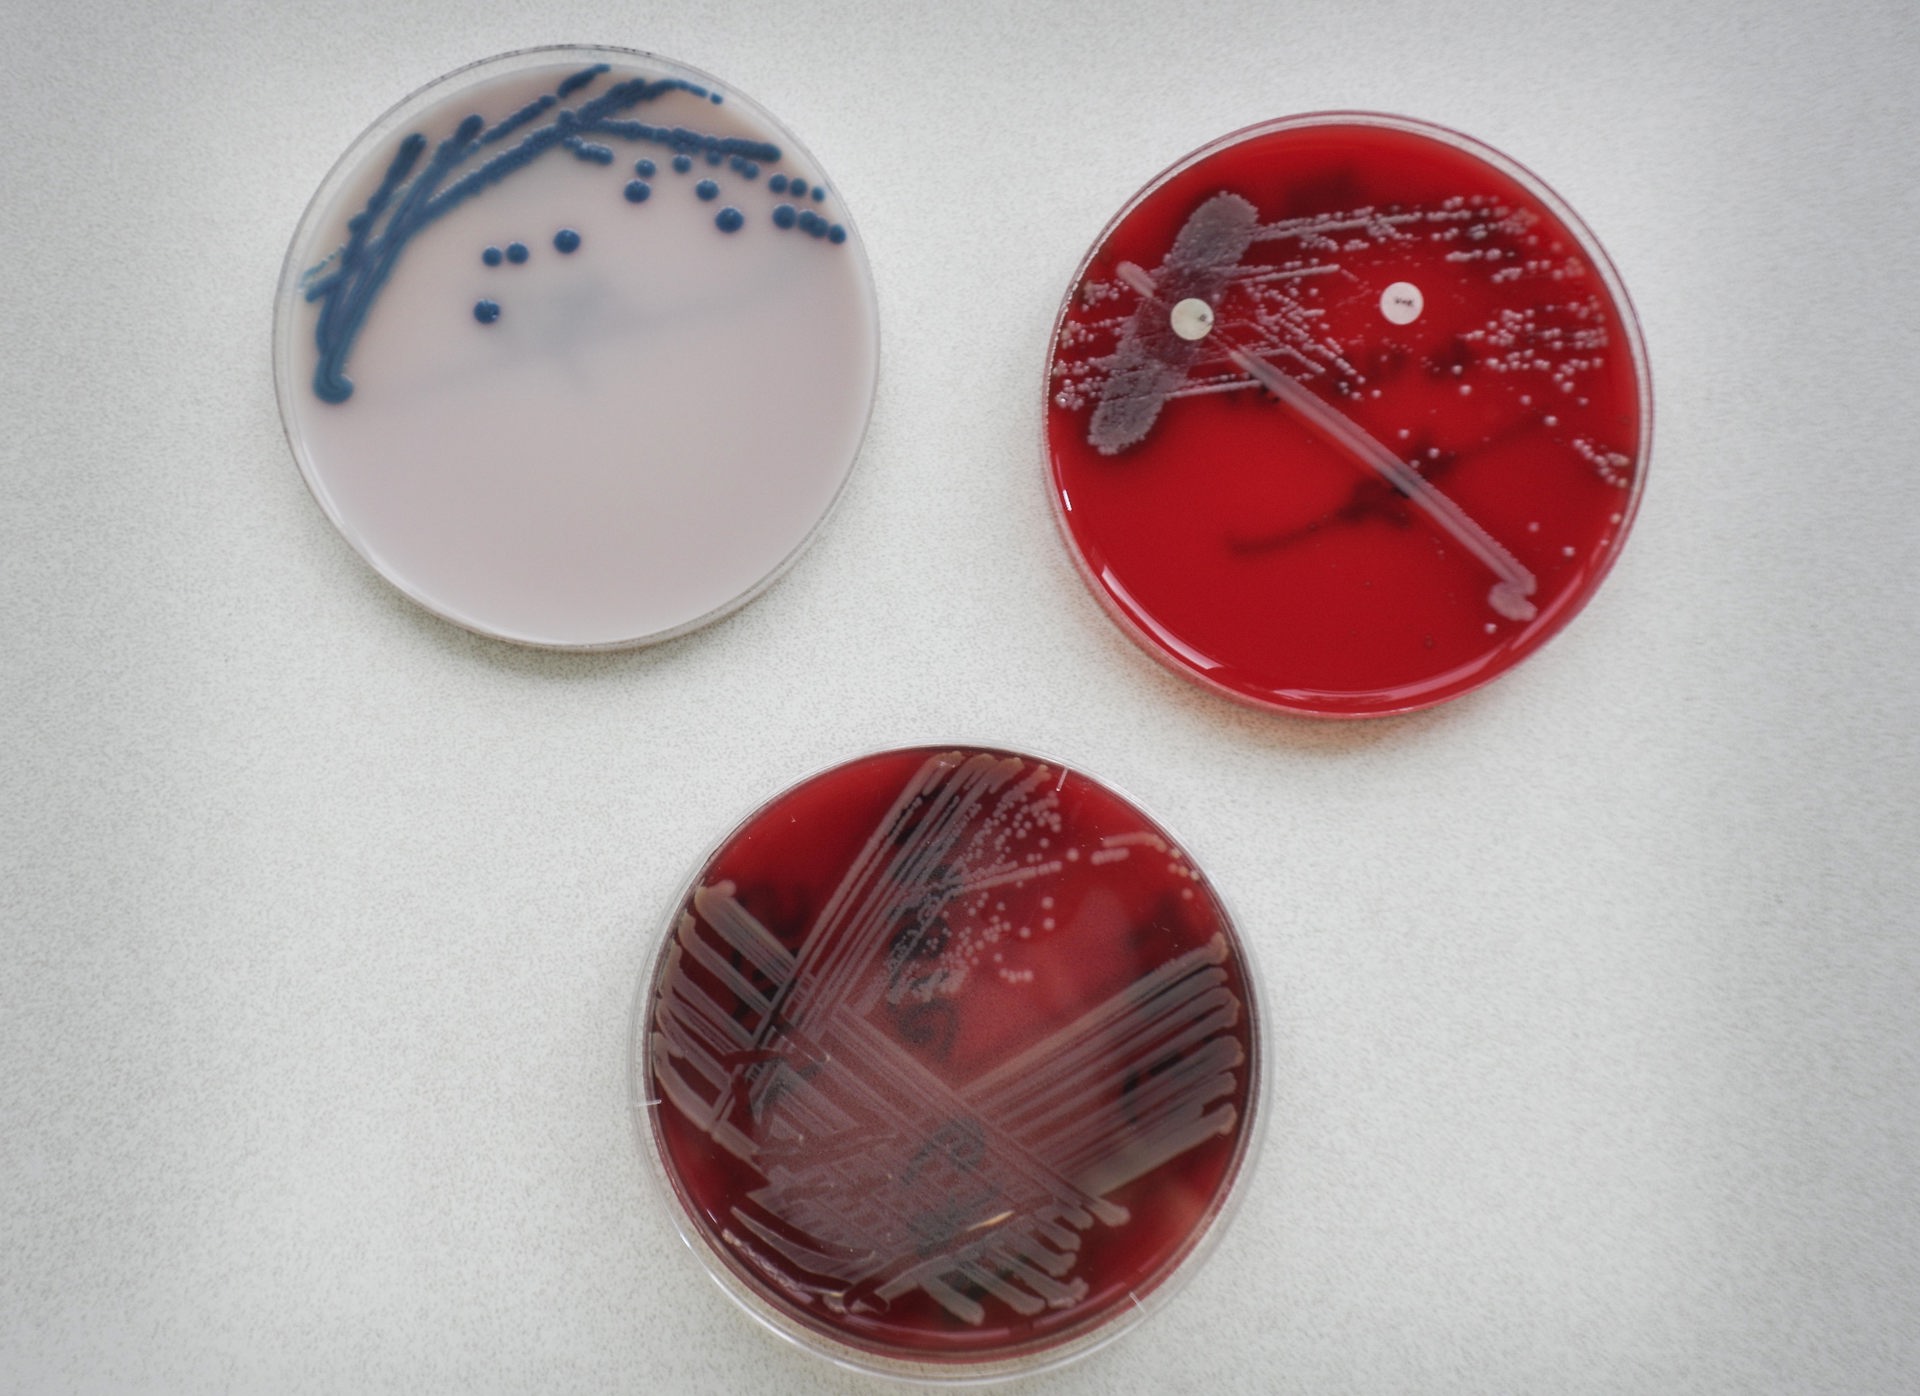

Praha
Laboratoř klinické mikrobiologie
Informace o pracovišti
Umístění pracoviště
Nagano Park 1, 1. patro
Provozní doba příjmu biolog. materiálu
Po - Pá 7.00 - 17.30 hodin
Provozní doba laboratoře
Po - Pá 7.00 - 15.30 hodin
So 7.00 - 12.00 hodin
Pohotovostní služba laboratoře
Po - Pá 15.30 – 17.30 hodin

Laboratoř klinické mikrobiologie
Vedoucí Laboratoře
MUDr. Zuzana Semeráková